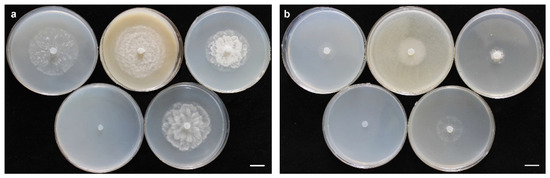
Jof 10 00405 g004

Abstract
An investigation into oomycete diversity in rice paddies of Fars Province in Iran led to the identification of two new Pythium sensu lato (s.l.) species as Globisporangium izadpanahii sp. nov. and Pythium banihashemianum sp. nov. The identification was based on morphological and physiological features as well as on the phylogenetic analysis of nuclear (ITS and βtub) and mitochondrial (cox1 and cox2) loci using Bayesian inference and Maximum Likelihood. The present paper formally describes these two new species and defines their phylogenetic relationships with other congeneric species. According to multiple gene genealogy analysis, G. izadpanahii sp. nov. was grouped with other species of Globisporangium (formerly, clade G of Pythium s.l.) and was closely related to both G. nagaii and the recently described G. coniferarum. The second species, designated P. banihashemianum sp. nov., was grouped with other species of Pythium sensu stricto (formerly, clade B of Pythium s.l.) and, according to the phylogenetic analysis, shared an ancestor with P. plurisporium. The production of globose hyphal swellings was a major characteristic of G. izadpanahii sp. nov., which did not produce vesicles and zoospores. In pathogenicity tests on rice seedlings, P. banihashemianum sp. nov. isolates were highly pathogenic and caused severe root and crown rot, while G. izadpanahii sp. nov. isolates were not pathogenic.
1. Introduction
Pythium sensu lato (s.l.) Pringsh. is a cosmopolitan, morphologically and genetically heterogeneous oomycete genus comprising more than 230 described species [1]. Several species of this genus have been reported as both facultative saprobes and plant, animal, and human pathogens [2,3,4,5,6,7,8]. Many other species have been reported as exclusively saprobes or even beneficial antagonists of plant pathogens [9,10,11,12,13,14,15]. Plant pathogenic species cause pre- and post-emergence damping off of seedlings, resulting in seed rot or the death of seedlings prior to emergence or the death of seedlings following emergence, respectively, as well as crown and root rot and may have a highly destructive impact on crops.
In the light of advances in molecular biology techniques, the genus Pythium s.l. was re-examined and divided into 11 phylogenetic clades (from A to K), based on the analysis of the ITS region of rDNA [16]. From this early study, it was clear that this genus was paraphyletic. Subsequently, multiple gene genealogy confirmed this assumption and Pythium s.l. was split into five distinct genera. These genera include Pythium sensu stricto (hereafter referred to as Pythium, encompassing clades A, B, C, and D), Elangisporangium (corresponding to clade H), Globisporangium (encompassing clades E, F, G, and I), Phytopythium (syn. Ovatisporangium, corresponding to clade K), and Pilasporangium, the last not coinciding with any of the 11 phylogenetic clades [17,18,19]. Each genus has its own unique morphological features, i.e., Pythium s.s. produces filamentous, filamentous inflated, or lobate sporangia. Globisporangium species produce globose to subglobose sporangia, occasionally with internal proliferation [1,17,18]. In addition, Phytopythium species produce ovoid sporangia with internal or external proliferation, resembling sporangia of Phytophthora species, while Elangisporangium and Pilasporangium produce elongated sporangia and sporangia without proliferation, respectively [17,19].
Before the advent of molecular techniques, the identification of species of Pythium s.l. was problematic mainly due to pleomorphism of the sexual and asexual structures, the intraspecific phenotypic variability, the inconsistency of isolates when forming some of these structures in vitro, and the lack of a comprehensive, sound taxonomic framework [20,21,22,23]. Although molecular techniques along with phylogenetic analyses have substantially assisted in the identification of Pythium s.l. species, morphological traits maintain a fundamental taxonomic relevance. Moreover, it is generally recognized that more than one molecular marker is needed for distinguishing most genera and species of oomycetes [23,24,25,26,27,28,29,30].
Several species of Pythium s.l. have been reported as rice seedling pathogens [31,32,33,34,35,36,37,38,39,40,41,42,43,44]. However, the diversity of Pythium s.l. populations in rice paddies has been little investigated worldwide.
More than 60 diverse taxa of Pythium s.l. have been reported from Iran [15,44]. In recent years, various cereal fields in Fars Province of Iran have been surveyed to isolate and identify Pythium s.l. species [42,43,44]. These studies revealed that rice paddies are a favorable ecological niche for Pythium s.l. species. During the surveys of rice paddies, we recovered two groups of Pythium s.l. isolates with distinctive characters that could not be assigned to any known species. Multi-locus phylogenetic inference indicated they were two new clearly distinct taxa. In the present study, these two groups were characterized and formally described as new species.
2. Materials and Methods
2.1. Isolation
From 2013 to 2015, rhizosphere soil, pond waters, and rice seedlings were randomly sampled in more than 40 diverse rice paddies and nurseries of Fars Province, Iran, most of which showed symptoms of pre- and post-emergence damping off and crown and root rot of seedlings. Geographic coordinates were recorded for each field by Global Positioning System (GPS) (Table 1). Samples were transported to the Mycology Laboratory of the Department of Plant Protection, Shiraz University, for isolation. Roots and basal stems of rice seedlings were washed with distilled water, blotted dry, cut into small segments (2 to 3 mm), and placed on the semi-selective medium for oomycetes CMA-PARP (extract of 40 g/L boiled ground corn; agar 15 g/L; amended with 10 µg/mL pimaricin, 200 µg/mL ampicillin, 10 µg/mL rifampicin, and 25 µg/mL PCNB) [45]. One hundred grams of each soil sample were placed in a plastic container and flooded with tap water to 1 cm above the soil surface [46]. Isolates were recovered from either soil or water samples by baiting with 5 mm surface-sterilized leaf disks of bitter orange (Citrus aurantium L.) or 5 mm pieces of sterile meadow grass (Poa annua L.) at 25 °C every 8 h for 48 h in total, and plating on CMA-PARP. Isolates were purified by the hyphal tip method on water agar (WA, agar 10 g/L) and stored on CMA (extract of 40 g/L boiled ground corn; agar 15 g/L) slopes at 15 °C.

Table 1.
List of Pythium sensu lato isolates recovered from rice paddy fields of Fars Province of Iran with their GenBank accession numbers.
2.2. Morphological Characterization
In order to observe asexual reproductive structures (sporangia, vesicles, and zoospores), isolates were transferred onto CMA containing sterile hemp (Cannabis sativa L.) seeds or turfgrass (Poa sp.) [47] for 24 h. The hemp seeds or turfgrass were then transferred to Petri dishes containing distilled water [48], sterile soil extract [49], or Schmitthenner solution [50] under a fluorescent light for 48 h and were checked every 8 h six times. Moreover, sporangia formation was examined using French bean agar media (FBA, extract of 30 g/L boiled French bean; agar 15 g/L [) [45] and sterile soil extract. Sexual reproductive structures were obtained with hemp seed agar (HSA, extract of 60 g/L boiled ground hemp seeds; agar 15 g/L) and carrot agar (CA, extract of 250 g/L boiled carrots; agar 15 g/L) incubated in darkness [47]. In order to study colony morphology, isolates were grown on CMA, HSA, CA, potato-dextrose agar (PDA, extract of 300 g/L boiled potatoes; dextrose 20 g/L; agar 15 g/L), and malt extract agar (MEA, malt extract 25 g/L; agar 15 g/L) [47]. Mycelium plugs (5 mm in diameter) from the edge of a 3 d old culture were placed in Petri dishes each containing 20 mm of medium. The dishes were incubated at 25 °C for 48 h. The effect of temperature on mycelium growth rate was tested on potato-dextrose carrot agar (PCA, extract of 20 g/L boiled potatoes; extract of 20 g/L boiled carrots, agar 15 g/L) [2] with three replicate Petri dishes per isolate and per each tested temperature. Dishes were incubated at 0, 5, 10, 15, 20, 25, 30, 35, and 40 °C.
2.3. DNA Extraction, PCR, Sequencing, and Phylogenetic Analyses
DNA was extracted using the method described by Mirsoleimani and Mostowfizadeh-Ghalamfarsa (2013) [51]. Primers used for the amplification and sequencing of nuclear (internal transcribed spacers 1, 2, and 5.8S gene of rDNA = ITS; β-tubulin gene = Btub) as well as mitochondrial (cytochrome c oxidase subunit II = cox2) loci in addition to the PCR conditions of loci are reported in Table S1. PCR products were purified and sequenced with the primers used for amplification by a dye terminator cycle (Bioneer, Daejeon, South Korea). Sequences were deposited into GenBank. For low-quality ITS sequences, cloning was performed using the Strata Cloning Kit (Agilent Technologies, Santa Clara, CA, USA) according to the manufacturer’s instruction [52].
The resulting sequences were edited and aligned by Geneious Prime 2022 [53] with subsequent visual adjustments. BLAST similarity searches were performed with blastn (for nucleotide-versus-nucleotide comparison) (Tables S2 and S3) [54]. Partition homogeneity tests were conducted on combined nuclear and mitochondrial gene alignments by PAUP* 4.0a136 [55] using 100 replicates and a heuristic general search option. To reconstruct the phylogenetic trees, Bayesian inference analyses on individual and concatenated ITS, Btub, cox1, and cox2 loci were carried out with MrBayes 3.1 [56], as implemented in TrEase [57] running 10 M generations with the GTR Gamma + I substitution model and discarding 25% of the initial trees as burnin. In addition, Maximum Likelihood inference was performed using RAxML as implemented in TrEase. All parameters were set to default. The robustness of the Maximum Likelihood trees was estimated by 1000 bootstraps. Phylogenetic trees were edited and displayed with Mega 11 [58].
2.4. Pathogenicity
With the exception of the Persepolis region (Table 1), pre- and post-emergence damping off, root rot, and in rare cases, crown rot were observed in 95% of the plants sampled from the selected regions. Hence, the ability of isolates to cause seed rot, stunting, and pre- and post-emergence damping off of rice seedlings was tested in pathogenicity assays. The inoculum was prepared according to the method described by Banihashemi (1989) [59], and Salmaninezhad and Mostowfizadeh-Ghalamfarsa (2019a) [42] using vermiculite amended with 120 mL/L hemp seed extract (extract of 60 g boiled hemp seeds) colonized by the mycelium.
For the pre-emergence damping off tests, rice seeds were washed and planted in pots containing sandy loam soil (500 mL) infested with 10 mL of the inoculum. As a control, rice seeds were planted in pots containing sandy loam soil (500 mL) mixed with 10 mL of sterile vermiculite amended with hemp seed extract. For the post-emergence damping off tests, 20 day old seedlings were transplanted into pots containing sandy loam soil (500 mL) infested with 10 mL of the inoculum. As a control, seedlings were transplanted into pots containing sandy loam soil (500 mL) mixed with 10 mL of sterile vermiculite amended with hemp seed extract. Symptoms were scored two weeks later. Re-isolations were performed from both symptomatic and control seedlings using CMA-PARP medium, according to the method described by [60].
3. Results
3.1. Morphology of Isolates of Pythium s.l.
Overall, 1169 isolates of Pythium s.l. were recovered from rice paddies of Fars Province during the survey. Among them, two groups of isolates with distinctive morphological characteristics were selected for further characterization in this study. Isolates of the first group (16 isolates) produced filamentous to slightly inflated sporangia which released zoospores in aqueous medium. Isolates of the other group (five isolates) produced globose to subglobose hyphal swellings and were not able to produce zoospores. Neither of these two groups of isolates corresponded to the already described species, according to the identification keys of Van der Plaäts-Niterink [2] and Dick [61]. Based on the morphologies of both colonies on different agar media and sexual structures, it was possible to distinguish two different subgroups within the first and more numerous group of isolates, which were designated as Morphotype I and II, respectively (see Section 3.4).
3.2. Phylogenetic Analyses
Isolates within each group had identical sequences of nuclear and mitochondrial loci, except for ITS sequences in which some strains showed minor differences. The final alignment length was 877 bp for ITS, 393 bp for cox1, 488 bp for cox2, 459 bp for Btub, and 2045 bp for combined gene regions as regards Pythium sp.; and 1317 bp for ITS, 393 bp for cox1, 484 bp for cox2, 480 bp for Btub, and 2709 bp for combined gene regions as regards Globisporangium sp. The ITS sequences of isolates of the first group showed 99% similarity with P. plurisporium Abad, Shew & L. T. Lucas and two other undescribed Pythium species. The ITS sequences of isolates of the second group showed 87 to 88% similarity with G. coniferarum Salmaninezhad & Mostowf., three undescribed Pythium species, and G. nagaii (Ito & Tokun) Uzuhashi, Tojo, & Kakish. The cox1 sequences of isolates of the first group showed 98.47% similarity with P. plurisporium. The cox1 sequences of isolates of the second group showed 97.96% similarity with G. coniferarum. The cox2 sequences of isolates of the first group showed 96.51% similarity with P. plurisporium. The cox2 sequences of isolates of the second group showed 98.42% similarity with G. coniferarum. The βtub sequences of isolates of the first group showed 98.47% similarity with P. plurisporium. The βtub sequences of isolates of the second group showed 97.41% similarity with G. coniferarum. In all phylogenetic trees (Figure 1, Figure 2, Figures S1 and S2), each group of isolates formed a well-supported monophyletic group, confirming the conclusion that the two groups were novel species. Bayesian posterior probability was 1.00 for each new lineage in the combined tree and ranged from 0.93 to 1.00 across nuclear and mitochondrial gene trees (Figures S3–S8). Nucleotide differences among the isolates with their sister taxa are shown in Tables S4 and S5. The two novel species were designated as Pythium banihashemianum sp. nov. and Globisporangium izadpanahii sp. nov., respectively. Pythium banihashemianum sp. nov. was located in clade B of the ITS phylogenetic tree and was related to P. plurisporium, P. kashmirense Paul, P. afertile Kanouse & Humphery, P. rhizo-oryzae Paul, P. graminicola Subraman, P. vanterpoolii Kouyeas & Kouyeas, and P. torulosum Cocker & Patt.



Figure 1.
Phylogenetic relationships of Pythium banihashemianum sp. nov. from paddy fields of Fars Province among 46 Pythium sensu stricto species based on the analysis of multigene genealogies of nuclear (ITS and Btub) and mitochondrial (cox1 and cox2) sequences in Maximum Likelihood tree. Numbers on branches represent posterior probability based on Bayesian analysis and the bootstrap support based on Maximum Likelihood, respectively.

Figure 2.
Phylogenetic relationships of Globisporangium izadpanahii sp. nov. from paddy fields of Fars Province among 46 Globisporangium species based on the analysis of multigene genealogies of nuclear (ITS and Btub) and mitochondrial (cox1 and cox2) sequences in Maximum Likelihood tree. Numbers on branches represent posterior probability based on Bayesian analysis and the bootstrap support based on Maximum Likelihood, respectively.
Globisporangium izadpanahii sp. nov. was located in clade G of the ITS phylogenetic tree and was related to G. coniferarum, G. nagaii, G. okanoganense (Lipps) Uzuhashi, Tojo, & Kakish, G. paddicum (Hirane) Uzuhashi, Tojo, & Kakish, G. iwayamai (Ito) Uzuhashi, Tojo, & Kakish, G. canariense (Paul) Uzuhashi, Tojo, & Kakish, G. violae (Chesters & Hickman) Uzuhashi, Tojo, & Kakish, and G. cederbergense (Bahramisharif, Botha, & Lamprecht) Nguyen & Spies. The position of each new species was consistent in all phylogenetic trees. Only the cox1 phylogenetic tree of Globisporangium species showed polytomy (Figure S4), while no polytomy was observed in other phylogenetic trees (Figures S1–S3 and S5–S8).
3.3. Pathogenicity
In pathogenicity tests (Table 2), P. banihashemianum sp. nov. was pathogenic on rice. The isolates of these species caused pre- and post-emergence damping off, crown rot (Figure 3), seed rot, and a severe decrease in growth rate. They were re-isolated from symptomatic seedlings. Conversely, control seedlings did not show any symptoms. Isolates of G. izadpanahii sp. nov. did not induce any disease in seeds or rice seedlings and could not be re-isolated from the roots and crowns of tested plants (Table 2).


Figure 3.
Pathogenicity tests on roots and crown of rice (Oryzae sativa). Pythium banihashemianum sp. nov. (068B1) causes root and crown (blue arrow) rot ((left) control; (right) infected crown and roots). Bar = 1 cm.

Table 2.
Pathogenicity results of the Pythium sensu lato species examined in this study.
3.4. Taxonomy
MycoBank: MB824523
Typification: IRAN, Fars Province: Kamfiruz (30°16.934′ N–052°19.155′ E), from roots of Oryza sativa, 16 August 2015, F. Salmaninezhad 068B1 (holotype CBS 143876, living culture preserved in a metabolically inactive state at Westerdijk Fungal Biodiversity Institute). GenBank: ITS = KX228083; βtub = KX228113; cox1 = OP321097; and cox2 = KX228120.
Etymology: After Prof. Ziaeddin Banihashemi, who is a pioneer in oomycete studies in Iran.
Although no differences were observed in the sequences of isolates assigned to this species, their morphological characteristics were distinct, leading to their division into two morphological groups (morphotypes).
Morphotype I: Colonies on PDA and HSA show a rosette pattern, on CA show an intermediate pattern, and on MEA and CMA show chrysanthemum and radial patterns, respectively (Figure 4a). Main hypha: 3.1–4.5 (av. 3.5) μm width. Sporangia: not observed on solid media but produce abundantly in aqueous medium containing sterile hemp seeds, filamentous, slightly inflated to rarely dendroid (Figure 5a). Zoospores: released through a discharge tube 50–110 μm long. Hyphal swellings: not present. Oogonia: smooth, rarely globose [29.8–37.4 (av. 33.3) µm], ovoid, jug shaped, sometimes without any specific shape (Figure 5i,j), mostly (more than 80%) with two adjacent projections. Oogonial projections: 0.5–0.9 (av. 0.7) µm long (Figure 5c). Antheridia: 4–8 per oogonium, clavate, and crook-necked, making apical or lateral contact, paragynous, monoclinous, and diclinous with a very long stalk, which mostly encircles around oogonia (Figure 5j). Each oogonium contains more than one oospore (up to 3). Oospores: aplerotic, globose to subglobose, 28.1–35.5 (av. 32.5) µm diam., with a wall 1.4–2 (av. 1.7) µm thick. Oospore formation is specific, and the oogonium stalk initially swells, leading to the first oospore formation. Subsequently, the terminal section of the oogonium swells, and the oospore moves into this section resulting in the formation of a second oospore in the oogonium swollen stalk (Figure 5c). Comparisons of the morphological characteristics of the isolates assigned to P. banihashemianum sp. nov. Morphotype I with its sister taxa are shown in Table 3. Morphometric features of the examined isolates are shown in Table S6. Colonies on PCA have an average radial growth rate of 2.5 mm d−1 at 10 °C, 5 mm d−1 at 15 °C, 7 mm d−1 at 20 °C, 10 mm d−1 at 25 °C and 30 °C, 11 mm d−1 at 35 °C, 1 mm d−1 at 40 °C, and no growth occurred at 5 °C. Cardinal temperatures: minimum 10 °C, optimum 35 °C, and maximum 40 °C (Figure 6).

Figure 4.
Colony morphology of Pythium banihashemianum sp. nov. Morphotype I isolate 068B1 (a), P. banihashemianum sp. nov. Morphotype II, isolate KC5 (b) after 24 h on various media at 25 °C; top (from left to right): carrot agar, malt extract agar, and potato-dextrose agar; bottom (from left to right): cornmeal agar and hemp seed agar. Bar = 1 cm.

Figure 5.
Morphological structures of Pythium banihashemianum sp. nov. (a) Filamentous sporangium (Morphotype I); (b) catenulate oospores with two paragynous antheridia (arrows) per oogonium (Morphotype II); (c) formation of oospore in an oogonium with two papillae (Morphotype I); (d) oogonium with single oospore and a long papilla (arrows; Morphotype II); (e) slightly inflated filamentous sporangium; (f) oogonium with single oospore showing two symmetrical papillae (Morphotype II); (g) catenulate oospores with both mono- and diclinous antheridia (Morphotype II); (h) catenulated aplerotic oospore with diclinous antheridium (arrows; Morphotype II); (i) oogonium with two oospores (left) and aplerotic oospore with two antheridia (right) (Morphotype I); (j) amorphous catenulated oogonia with hypogynous antheridium (arrows; Morphotype I). Bars = 10 µm, except for e and o where Bar = 20 µm.

Figure 6.
Average radial growth rates of Pythium banihashemianum sp. nov. (16 isolates) and Globisporangium izadpanahii sp. nov. (five isolates) on potato-dextrose carrot agar at different temperatures.

Table 3.
Morphological comparison of the species described in this study with their related species.
Morphotype II: Colonies show a radial pattern on CA and HSA, a uniform pattern on CMA, an intermediate pattern on PDA, and no specific pattern on MEA (Figure 4b). Main hyphae: 2.7–4.0 (av. 3.1) μm in width. Sporangia: filamentous and inflated, never observed on solid media and produced abundantly on aqueous medium with sterile hemp seeds. (Figure 5e). Zoospores: released after 12 h from 61–115 μm long discharge tubes. The mycelium grows easily on HSA and CA, producing abundant oogonia, antheridia, and oospores. Two kinds of oospore formation are observed: single (Figure 5f) and catenulate (Figure 5b,g). Oogonia: smooth, globose 28.1–40.5 (av. 38.3) μm, terminal, mostly with more than one oospore (up to 5 with catenulate formation) (Figure 5b,g,h). More than 80% of the oogonia contain two papillae on both sides which are 1.1–2.3 (av. 1.7) µm long (Figure 5d). Antheridia: 1–2 per oogonia with catenulate oospores and rarely (less than 5%) up to 4 per oogonia with a single oospore, crook-necked, making apical contact, paragynous, mostly monoclinous, rarely diclinous. Oospores: globose, aplerotic, smooth, most (more than 90%) catenulate, 26.7–36.4 (av. 32.4) µm diam., with a wall 0.8–3.0 (av. 1.5) µm thick. Comparisons of the morphological characteristics of the isolates assigned to P. banihashemianum sp. nov. Morphotype II with its sister taxa are shown in Table 3. Morphometric features of the examined isolates are shown in Table S6. Colonies on PCA have an average radial growth rate of 1 mm d−1 at 5 °C, 2 mm d−1 at 10 °C, 3 mm d−1 at 15 °C, 5 mm d−1 at 20 °C, 7 mm d−1 at 25 °C, 12 mm d−1 at 30 °C, 9 mm d−1 at 35 °C, and 1 mm d−1 at 40 °C. Cardinal temperatures: minimum 5 °C, optimum 30 °C, and maximum 40 °C (Figure 6).
Other specimens examined: IRAN. Fars Province: Kamfiruz (30°11.017′ N–052°27.900′ E), from rhizosphere of Oryzae sativa, 16 August 2015, F. Salmaninezhad K116-1. IRAN, Fars Province: Kamfiruz (30°11.845′ N–052°27.787′ E), from pond water of paddy fields, 20 May 2014, F. Salmaninezhad K101-4. IRAN, Fars Province: Kamfiruz (30°11.911′ N–052°27.777′ E), from rhizosphere of O. sativa, 20 May 2014, F. Salmaninezhad G112-2. IRAN, Fars Province: Kamfiruz (30°11.909′ N–052°27.779′ E), from the soil of paddy fields, 20 May 2014, F. Salmaninezhad 056S2. IRAN, FARS Province: Ramjard (30°07.274′ N–052°32.946′ E), from rhizosphere of O. sativa, 9 November 2015, F. Salmaninezhad 033B7. IRAN, Fars Province: Ramjard (30°07.234′ N–052°32.983′ E), from roots of O. sativa, 9 November 2015, F. Salmaninezhad 038C3. IRAN, Fars Province: Ramjard (30°02.780′ N–052°49.513′ E), from the roots of O. sativa, 9 November 2015, F. Salmaninezhad 048S1. IRAN, Fars Province: Firuz Abad (28°51.587′ N–052°30.842′ E), from rhizosphere of O. sativa, 20 May 2014, F. Salmaninezhad F201-3. IRAN, Fars Province: Firuz Abad (28°51.407′ N–052°30.666′ E), from O. sativa roots, 9 November 2015, F. Salmaninezhad Fk21. GenBank: ITS = MK454539; βtub = MK540655; cox1 = OP321098; cox2 = MK455862. IRAN, Fars Province: Firuz Abad (28°49.735′ N–052°29.149′ E), from O. sativa roots, 9 November 2015, F. Salmaninezhad Fs301. IRAN, Fars Province: Firuz Abad (28°49.989′ N–052°29.551′ E), from rhizosphere of O. sativa, 20 May 2014, F. Salmaninezhad F32-01. IRAN, Fars Province: Persepolis (29°59.008′ N–052°49.513′ E), from rhizosphere of O. sativa, 16 August 2015, F. Salmaninezhad Th641. GenBank: ITS = MK454538; βtub = MK540656; cox1 = OP321102; cox2 = MK455863. IRAN, Fars Province: Persepolis (29°58.892′ N–052°57.734′ E), from rhizosphere of O. sativa, 16 August 2014, F. Salmaninezhad KC5. GenBank: ITS = MK454707; βtub = MK455865; cox1 = OP321099; cox2 = MK455856. IRAN, Fars Province: Ramjard (30°05.901′ N–052°35.482′ E), from O. sativa roots, 16 August 2014, F. Salmaninezhad KCr09. GenBank: ITS = MK454706; βtub = MK455864; cox1 = OP321101; cox2 = MK455857. IRAN, Fars Province: Ramjard (30°05.476′ N–052°35.563′ E), from O. sativa crown, 9 November 2015, F. Salmaninezhad KC11 (CBS 143875). MB824524. GenBank: ITS = KX228081; βtub = MK455866; cox1 = OP321100; cox2 = MK455858.
Notes: This species belongs to clade B of the ITS phylogenetic tree sensu Lévesque and de Cock [16] and is closely related to P. plurisporium (Figure 1). Pythium banihashemianum sp. nov. differs from all other Pythium species from clade B due to its high-temperature tolerance and amorphous oogonia with more than one oospore, and from P. plurisporium due to it producing a high proportion of papillate oogonia, containing more than one papilla in most oogonia, the presence of two papillae on oogonia, the special formation of oospores, and its unique sequences of mitochondrial and nuclear genes. Adjacent papillae were abundant in isolate 068B1.
Globisporangium izadpanahii Salmanin. & Mostowf. sp. nov. (Figure 2, Figure 4, Figure 6, Figure 7 and Figure 8)
MycoBank: MB824525
Typification: IRAN, Fars Province: Firuz Abad (28°49.989′ N–052°29.551′ E), from rhizosphere of Oryzae sativa nursery, 9 November 2015, F. Salmaninezhad K330-7 (holotype CBS 144006, living culture preserved in a metabolically inactive state at Westerdijk Fungal Biodiversity Institute). GenBank: ITS = MK454537; βtub = MK455869; cox1 = OP321103, cox2 = MK455859.
Etymology: After Prof. Keramatollah Izadpanah, who is a leading phytopathologist in Iran.
Colonies on PDA and MEA show a rosette pattern, and on HSA, CMA, and CA, a radial pattern (Figure 7). Sporangia and zoospores: not produced. Hyphal swelling: terminal or intercalary, formed in aqueous medium after one week, 12.9–13.7 (av. 13.2) µm in diam, never observed on solid media (Figure 8a). Main hyphae: 4.0–4.8 (av. 4.3) µm in width. Oogonia: globose, smooth, terminal, or intercalary, 62.0–63.9 (av. 63.0) µm diam (Figure 8c–d), and most contain a needle-shaped papilla up to 0.8–3.1 (av. 1.0 µm) long (Figure 8d). Antheridia: just one per oogonium, crook-necked, elongated, and clavate, mostly monoclinous, rarely diclinous, making apical contact with the oogonium, paragynous and sometimes hypogynous (Figure 8b,d). Oospores: globose, perfectly plerotic, with a wall which is up to av. 9.2 µm thick. Comparisons of the morphological characteristics of the isolates assigned to G. izadpanahii sp. nov. with its sister taxa are shown in Table 3. Morphometric features of the examined isolates are shown in Table S6. Colonies on PCA have an average radial growth rate of 1 mm d−1 at 10 °C, 3.5 mm d−1 at 15 °C, 5 mm d−1 at 20 °C, 7 mm d−1 at 25 °C, 2 mm d−1 at 30 °C, 1 mm d−1 at 35 °C, and no growth at 5 °C and 40 °C. Cardinal temperatures: minimum 10 °C, optimum 25 °C, and 35 °C (Figure 6).
Other specimens examined: IRAN, Fars Province: Kamfiruz (29°58.823′ N–052°53.651′ E), from Oryzae sativa crown, 9 November 2015, F. Salmaninezhad KGr1. GenBank: ITS = MK454535; βtub = MK455867; cox1 = OP321105; cox2 = MK455861. IRAN, Fars Province: Ramjard (30°06.139′ N–052°26.892′ E), from rhizosphere of Oryzae sativa, 9 November 2015, F. Salmaninezhad Rfa01. IRAN, Fars Province: Kamfiruz (30°18.134′ N–052°17.767′ E), from rhizosphere of O. Sativa, 9 November 2015, F. Salmaninezhad Kha3. IRAN, Fars Province: Kamfiruz (30°19.236′ N–052°16.560′ E), from pond water of paddy fields, 9 November 2015, F. Salmaninezhad KB14. GenBank: ITS = MK454536; βtub = MK455868; cox1 = OP321104; cox2 = MK455860.
Notes: This species belongs to clade G of the ITS phylogenetic tree sensu Lévesque and de Cock [16] in the vicinity of G. coniferarum and G. nagaii (Figure 1). Globisporangium izadpanahii sp. nov. does not form sporangia and zoospores under standard conditions tested including different temperatures. However, the formation of hyphal swellings in aqueous medium after one week, the unique type of oogonia with a long needle-shaped papilla, its strictly plerotic oospores, it special and unique growth pattern on various media, and, especially, the presence of an elongated clavate antheridium differentiated this species from other known Globisporangium species. Additionally, the unique sequences of mitochondrial and nuclear genes separated G. izadpanahii sp. nov. from other species.



Figure 7.
Colony morphology of Globispirangium izadpanahii sp. nov. isolate K330-7 after 24 h on various media at 25 °C; (top) (from left to right): carrot agar, malt extract agar, and potato-dextrose agar; (bottom) (from left to right): cornmeal agar and hemp seed agar. Bar = 1 cm.

Figure 8.
Morphological structures of Globisporangium izadpanahii sp. nov. (a) hyphal swellings; (b) intercalary oogonium with a single clubbed shape antheridium; (c) smooth oogonium with paragynous antheridium; (d) perfectly plerotic oospore with a long papilla. Bars: = 10 µm.
4. Discussion
This study is part of a larger research project aimed at investigating the diversity of Pythium s.l. populations in rice paddies of Fars Province in Iran. Among more than a thousand Pythium s.l. isolates recovered, 16 already known species and three new Pythium species, P. heteroogonium, P. longipapillum, and P. oryzicollum, had previously been identified on the basis of morphological and molecular traits [42,44]. In the present study, two groups of isolates from the same large set of isolates, previously recovered from rice paddies, were characterized. The two groups, showing distinctive morphological characters and forming two separate well-supported monophyletic lineages, were formally described as new species, P. banihashemianum sp. nov. and G. izadpanahii sp. nov., respectively. The species diversity of Pythium s.l. in rice paddies of Fars Province [42,44] indicate that the aquatic environment of this peculiar type of managed ecosystem provides a favorable ecological niche to these oomycetes.
Pythium banihashemianum sp. nov. was grouped within clade B of the ITS phylogenetic tree of Pythium sensu stricto, but in a separate lineage from other known species. The closest relatives of this species are P. plurisporium, P. kashmirense, and P. afertile. The isolates assigned to P. banihashemianum sp. nov. were in turn split into two diverse morphotypes. Both morphotypes produced filamentous-type sporangia. However, the sporangia produced by Morphotype I were mostly dendroid while Morphotype II produced mostly inflated sporangia. In contrast to Morphotype I, which produced one to three oospores in a single oogonium, Morphotype II produced mostly one oospore per oogonium. In addition, the presence of asymmetrical oogonia with papillae separates Morphotype I from Morphotype II, which formed catenulated globous oogonia. The number of antheridia per oogonium was up to eight in Morphotype I and occasionally up to four in Morphotype II. Thus, great intraspecific morphological variability is a rare yet interesting phenomenon that was previously reported for P. plurisporium, a closely related species to P. banihashemianum sp. nov., [62]. Pythium plurisporium isolates form two different types of oogonia, with a single oospore or with more than one oospore [62,63]. While both P. banihashemianum sp. nov. and P. plurisporium may produce more than one oospore per oogonium, the maximum number of oospores per oogonium in P. banihashemianum sp. nov. (up to at most 3) is less than that in P. plurisporium (up to 6) [62,63]. Moreover, the ability of P. banihashemianum sp. nov. to produce single oospores clearly separates it from P. plurisporium and any other known Pythium species.
The existence of sexual structures in P. banihashemianum sp. nov. clearly separates it from P. afertile, which does not reproduce sexually. Pythium kashmirense and Morphotype II of P. banihashemianum sp. nov. have sporangial type in common; however, in P. kashmirense, antheridial filaments coil around the oogonial stalks [64]. Although ITS and βtub phylogenetic trees could not differentiate P. banihashemianum sp. nov. from P. plurisporium, mitochondrial loci phylogeny clearly separated them from each other, indicating P. banihashemianum sp. nov. is a new distinct species. Consistently with Robideau et al. [23] and Hyde et al. [1], more than one gene phylogeny was needed to separate P. banihashemianum sp. nov. from P. plurisporium.
Although polytomy was observed in cox1 loci analyses, G. izadpanahii sp. nov.’s location in clade G was highly supported by analyzing other loci. Polytomy in cox1 analyses was also observed previously in Pythium s.l. [1,23]. A specific type of antheridia, and the absence of sporangia, vesicles, or zoospores separated G. izadpanahii sp. nov. from other described species. Globisporangium izadpanahii sp. nov. exhibits significant variations in form and structure when compared to its sister species G. coniferarum and G. nagaii. In contrast to G. izadpanahi sp. nov., G. coniferarum produces ovoid to ellipsoid sporangia with vesicles and zoospores [54]. Furthermore, one of the key characteristics of G. coniferarum is the production of abundant chlamydospores and different shapes of oogonia (from globose to ovoid and ellipsoid) [52], while in G. izadpanahii sp. nov. chlamydospores and oogonia were exclusively globose. The production of terminal, ovoid to pyriform, and proliferating sporangia in G. nagaii [2] also separates it from G. izadpanahii sp. nov. Additionally, in G. nagaii, oogonia are terminal and globose, with aplerotic oospores, and the antheridia disappear soon after fertilization [2]. Such characters have never been observed in G. izadpanahii sp. nov. Even though G. izadpanahii sp. nov. is a member of clade G, other members of this clade show no similar morphological characteristics to this species.
The presence of multiple divergent copies of the ITS region is a well-known phenomenon among Pythium s.l. species and was reported previously for G. coniferarum [52]. Analysis of the ITS sequences of Globisporangium izadpanahii sp. nov. clones showed that the ITS region had many insertions, which led to the overlapping of the direct sequences, disruption of the electropherograms, and, consequently, low-quality sequences. Furthermore, G. izadpanhaii sp. nov. isolates showed intraspecific ITS sequence heterogeneity. Using the resulting contigs of ITS clones, we showed that G. izadpanahii sp. nov. is a new species located in a separate lineage close to G. nagaii. Other loci sequences (i.e., Btub, cox1, and cox2) showed a very high quality and strongly supported the separation of this new species.
Although all isolates characterized in this study were recovered from rice paddies and rice plants showing severe symptoms of root and crown rot, pathogenicity tests revealed that P. banihashemianum sp. nov. isolates were extremely pathogenic and caused severe symptoms on rice seedlings, while G. izadpanahii sp. nov. isolates were not pathogenic on rice seedlings.
The discovery of two new species, P. banihashemianum sp. nov. and G. izadpanahii sp. nov., provides new insight into the diversity of oomycetes. The advent of molecular techniques and multigene phylogenetic analysis has greatly contributed to the advancement of the systematics of oomycetes, and they are valuable tools when setting up a sound internationally recognized taxonomic framework. Numerous new cryptic species were separated from species complexes and polyphyletic genera, like Pythium s.l., and were split into clearly separate genera, differing also in morphological and physiological features [19,65]. However, a putative new taxon cannot be regarded as a species until its hierarchical status has been determined and its name has been formally designated according to the rules of the International Code of Nomenclature for algae, fungi, and plants [28]. The precise identification of a taxon has also phytopathological implications and is crucial for the effective management of plant diseases caused by oomycetes. For instance, of the two new species described in this study, both associated to symptomatic rice seedlings, only P. banihashemianum sp. nov. was proved to be pathogenic.
5. Conclusions
The description of two novel species, P. banihashemianum sp. nov. and G. izadpanahii sp. nov., in addition to those identified in previous studies, contributes to the advancement of the systematics of Pythium s.l. and supports its segregation into several distinct genera. Moreover, this study confirms that rice paddies are a wide repository of diversity of these oomycetes, which thrive in this type of ecosystem. In pathogenicity tests on rice seedlings, P. banihashemianum sp. nov. was proved to be an aggressive pathogen, while G. izadpanahii sp. nov. was not pathogenic, indicating species of Pythium s.l. may have multiple ecological roles in rice paddies. The agronomic, phytopathological, and taxonomic relevance of unveiling the diversity of Pythium s.l. populations in managed ecosystems, such as rice paddies, will encourage the extension of this study to other geographic areas and diverse cereal crops.
Supplementary Materials
The following supporting information can be downloaded at: https://www.mdpi.com/article/10.3390/jof10060405/s1, Figure S1: Phylogenetic relationships of Pythium banihashemianum from rice paddy fields of Iran among 60 Pythium s.s. species based on Maximum Likelihood of internal transcribed spacers 1, 2, and 5.8S gene of rDNA sequences. Numbers above the branches represent posterior probability based on Bayesian analysis, bootstrap support based on Maximum Likelihood analyses; Figure S2: Phylogenetic relationships of Globisporangium izadpanahii (from rice paddy fields of Iran among 75 Globisporangium species based on Maximum Likelihood analysis of internal transcribed spacers 1, 2, and 5.8S gene of rDNA sequences. Numbers above the branches represent posterior probability based on Bayesian analysis, bootstrap support based on Maximum Likelihood analyses; Figure S3: Phylogenetic relationships of Pythium banihashemianum from rice paddy fields of Iran among 58 Pythium s.s. species based on Maximum Likelihood analysis of cytochrome c oxidase subunit I sequences. Numbers above the branches represent posterior probability based on Bayesian analysis, bootstrap support based on Maximum Likelihood analyses; Figure S4: Phylogenetic relationships of Globisporangium izadpanahii from rice paddy fields of Iran among 61 Globisporangium species based on Maximum Likelihood analysis of cytochrome c oxidase subunit I sequences. Numbers above the branches represent posterior probability based on Bayesian analysis, bootstrap support based on Maximum Likelihood analyses; Figure S5: Phylogenetic relationships of Pythium banihashemianum from rice paddy fields of Iran among 54 Pythium s.s. species based on Maximum Likelihood analysis of cytochrome c oxidase subunit II sequences. Numbers above the branches represent posterior probability based on Bayesian analysis, bootstrap support based on Maximum Likelihood analyses; Figure S6: Phylogenetic relationships of Globisporangium izadpanahii from rice paddy fields of Iran among 75 Globisporangium species based on Maximum Likelihood analysis of cytochrome c oxidase subunit II sequences. Numbers above the branches represent posterior probability based on Bayesian analysis, bootstrap support based on Maximum Likelihood analyses; Figure S7: Phylogenetic relationships of Pythium banihashemianum from rice paddy fields of Iran among 33 Pythium s.s. species based on Maximum Likelihood analysis of Beta tubulin sequences. Numbers above the branches represent posterior probability based on Bayesian analysis, bootstrap support based on Maximum Likelihood analyses; Figure S8: Phylogenetic relationships of Globisporangium izadpanahii from rice paddy fields of Iran among 38 Globisporangium species based on Maximum Likelihood analysis of Beta tubulin sequences. Numbers above the branches represent posterior probability based on Bayesian analysis, bootstrap support based on Maximum Likelihood analyses; Table S1: List of primers used in this study with their PCR conditions; Table S2: Globisporangium spp. isolate codes and GeneBank accession numbers for phylogenetic analyses comparison; Table S3: Pythium sensu stricto isolate codes and GenBank accession numbers for phylogenetic analyses comparison; Table S4: Base pair differences across Btub, ITS, cox1, and cox2 sequences showing the inter- and intraspecific variation of Globisporangium izadpanahii (IZA) and other related species, including G. coniferarum (CON), G. nagaii (NAG), G. violae (VIO), G. okanoganense (OKA), G. canariense (CAN), G. monoclinum (MON), and G. iwayamae (IWA); Table S5: Base pair differences across Btub, ITS, cox1, and cox2 sequences showing the inter- and intraspecific variation of Pythium banihashemianum (BAN) and other related species, including P. plurisporium (PLU), P. afertile (AFE) and P. kashmirense (KAS); Table S6: Morphological characters and dimensions (µm) of Pythium sensu lato species recovered from rice paddies of Fars Province, Iran.
Author Contributions
Conceptualization, F.S. and R.M.-G.; methodology, F.S. and R.M.-G.; software, F.S. and R.M.-G.; validation, F.S. and R.M.-G.; formal analysis, F.S.; investigation, F.S.; resources, R.M.-G. and S.O.C.; data curation, F.S.; writing—original draft preparation, F.S.; writing—review and editing, F.S., R.M.-G. and S.O.C.; visualization, F.S.; supervision, R.M.-G.; project administration, R.M.-G.; funding acquisition, R.M.-G. and S.O.C. All authors have read and agreed to the published version of the manuscript.
Funding
This research was funded by the Iran National Science Foundation (INSF, award number 4001002).
Institutional Review Board Statement
Not applicable.
Informed Consent Statement
Not applicable.
Data Availability Statement
The datasets generated and analyzed during the current study are in Supplementary Tables or available from the corresponding author on reasonable request.
Acknowledgments
The authors also thank the Italy–Iran (2018–2019) mobility Program “PIETRO DELLA VALLE” for providing the opportunity to collaborate. The authors are grateful to the PRIMA project “Smart and Innovative Packaging, Postharvest Rot Management, and Shipping of Organic Citrus Fruit (BiOrangePack)”, funded by the European Union, and “S.A.I.A.—Soluzioni Automatizzate per l’Irrigazione degli Agrumi” co- funded with resources from the Notice of Implementation of Measure 16 “Cooperazione”, sottomisura 16.2, “Progetti pilota o introduzione di prodotti, pratiche, processi o tecnologie nuove” for inspiring the present study.
Conflicts of Interest
The authors declare no conflicts of interest.
References
- Hyde, K.D.; Nilsson, H.R.; Alias, S.A.; Ariuawansa, H.A.; Blair, J.E.; Cai, L.; de Cock, A.W.A.M.; Dissanayake, A.J.; Glockling, S.L.; Goonasekara, I.D.; et al. One stop shop: Backbones trees for important phytopathogenic genera: I (2014). Fungal Divers. 2014, 67, 21–125. [Google Scholar] [CrossRef]
- Van der Plaäts-Niterink, A.J. Monograph of the genus Pythium. Stud. Mycol. 1981, 21, 1–198. [Google Scholar]
- Czeczuga, B.; Mazalska, B.; Godlewska, A.; Muszynska, E. Aquatic fungi growing on dead fragments of submerged plants. J. Limnol. 2005, 35, 283–297. [Google Scholar] [CrossRef]
- Kawamura, Y.; Yokoo, K.; Tojo, M.; Hishiike, M. Distribution of Pythium porphyrae, the causal agent of red rot disease of Porphyrae spp., in the Ariake sea, Japan. Plant Dis. 2005, 89, 1041–1047. [Google Scholar] [CrossRef] [PubMed]
- Hwang, E.K.; Park, C.S.; Kakinuma, M. Physicochemical responses of Pythium porphyrae (Oomycota), the causative organism of red rot disease in Porphyra to acidification. Aquac. Res. 2009, 40, 1777–1784. [Google Scholar] [CrossRef]
- Li, W.; Zhang, T.; Tang, X.; Wang, B. Oomycetes and fungi: Important parasites on marine algae. Acta Oceanol. Sin. 2010, 29, 74–81. [Google Scholar] [CrossRef]
- Weiland, J.E.; Beck, B.R.; Davis, A. Pathogenicity and virulence of Pythium species obtained from forest nursery soils on Douglas-Fir seedlings. Plant Dis. 2012, 97, 744–748. [Google Scholar] [CrossRef] [PubMed]
- Ho, H.H. The genus Pythium in mainland China. Mycosystemata 2013, 32, 20–44. [Google Scholar]
- Elad, Y.; Lifshitz, R.; Baker, R. Enzymatic activity of the mycoparasite Pythium nunn during interaction with host and non-host fungi. Physiol. Plant Pathol. 1985, 27, 131–148. [Google Scholar] [CrossRef]
- Hockenhull, J.; Jensen, D.F.; Yudiarti, T. The use of Pythium periplocum to control damping-off of cucumber seedlings caused by Pythium aphanidermatum. In Biological Control of Plant Diseases-Progress and Challenges for the Future; Tjamos, E.C., Papavizas, G.C., Cook, R.J., Eds.; Springer: New York, NY, USA, 1992; pp. 203–206. [Google Scholar]
- Morajelo, E.; Clemente, A.; Descals, E.; Belbahri, L.; Calmin, G.; Lefort, F.; Spies, C.F.J.; McLeod, A. Pythium recalcitrans sp. nov. revealed by multigene phylogenetic analysis. Mycologia 2008, 100, 310–319. [Google Scholar]
- Kobayashi, S.; Uzuhashi, S.; Tojo, M.; Kakishima, M. Characterization of Pythium nunn newly recorded in Japan and its antagonistic activity against P. ultimum var. ultimum. J. Gen. Plant Pathol. 2010, 76, 278–283. [Google Scholar] [CrossRef]
- Horner, N.R.; Grenville-Bridge, L.J.; van West, P. The oomycete Pythium oligandrum expresses putative effectors during mycoparasitism of Phytophthora infestans and is amenable to transformation. Fungal Biol. 2012, 116, 24–41. [Google Scholar] [CrossRef] [PubMed]
- Bahramisharif, A.; Lamprecht, S.; Calitz, F.; McLeod, A. Suppression of Pythium and Phytophthora damping-off of Rooibos by compost and a combination of compost and nonpathogenic Pythium taxa. Plant Dis. 2013, 97, 1605–1610. [Google Scholar] [CrossRef] [PubMed]
- Mostowfizadeh-Ghalamfarsa, R. The current status of Pythium species in Iran: Challenges in taxonomy. Mycol. Iran. 2015, 2, 79–87. [Google Scholar]
- Lévesque, C.A.; de Cock, A.W.A.M. Molecular phylogeny and taxonomy of the genus Pythium. Mycol. Res. 2004, 108, 1363–1383. [Google Scholar] [CrossRef] [PubMed]
- Uzuhashi, S.; Tojo, M.; Kakishima, M. Phylogeny of the genus Pythium and description of new genera. Mycoscience 2010, 51, 337–365. [Google Scholar] [CrossRef]
- Baten, M.A.; Asano, T.; Motohashi, K.; Ishiguro, Y.; Rahman, M.Z.; Inaba, S.; Suga, H.; Kageyama, K. Phylogenetic relationships among Phytopythium species, and re-evaluation of Phytopythium fagopyri comb. nov., recovered from damped-off buckwheat seedlings in Japan. Mycol. Prog. 2014, 13, 1145–1156. [Google Scholar] [CrossRef]
- Nguyen, H.D.T.; Dodge, A.; Dadej, K.; Rintoul, T.L.; Ponomareva, E.; Martin, F.N.; de Cock, A.W.A.M.; Lévesque, C.A.; Redhead, S.A.; Spies, C.F.J. Whole genome sequencing and phylogenomic analysis show support for the splitting of genus Pythium. Mycologia 2022, 114, 501–515. [Google Scholar] [CrossRef] [PubMed]
- Martin, F.N. Phylogenetic relationships among some Pythium species inferred from sequence analysis of the mitochondrially encoded cytochrome oxidase II gene. Mycologia 2000, 95, 269–284. [Google Scholar] [CrossRef]
- de Cock, A.W.A.M.; Lèvesque, C.A. New species of Pythium and Phytophthora. Stud. Mycol. 2004, 50, 481–487. [Google Scholar]
- Bala, K.; Robideau, G.P.; Desaulniers, N.; de Cock, A.W.A.M.; Levesque, C.A. Taxonomy, DNA barcoding and phylogeny of three new species of Pythium from Canada. Persoonia 2010, 25, 22–31. [Google Scholar] [CrossRef] [PubMed]
- Robideau, G.P.; de Cock, A.W.A.M.; Coffey, M.D.; Volgmayr, H.; Brouwer, H.; Bala, K.; Chitty, D.W.; Desaulniers, N.; Eggertson, Q.A.; Gachon, C.M.; et al. DNA barcoding of oomycetes with cytochrome c oxidase subunit I and internal transcribed spacer. Mol. Ecol. Resour. 2011, 11, 1002–1011. [Google Scholar] [CrossRef] [PubMed]
- Villa, N.O.; Kageyama, K.; Asano, T.; Suga, H. Phylogenetic relationships of Pythium and Phytophthora species based on ITS rDNA, cytochrome oxidase II and β-tubuline gene sequences. Mycologia 2006, 98, 410–422. [Google Scholar] [PubMed]
- Rahman, M.Z.; Abdelzaher, H.M.A.; Mingzhu, L.; Motohashi, K.; Suga, H.; Kageyama, K. Pythium rishiriense sp. nov. from water and P. alternatum sp. nov. from soil, two new species from Japan. FEMS Microbiol. Lett. 2015, 362, fnv086. [Google Scholar] [CrossRef] [PubMed]
- Uzuhashi, S.; Okada, G.; Ohkuma, M. Four new Pythium species form aquatic environments in Japan. Antonie Leewenhoek 2015, 107, 375–391. [Google Scholar] [CrossRef] [PubMed]
- Uzuhashi, S.; Hata, K.; Matsuura, S.; Tojo, M. Globisporangium oryzicola sp. nov., causing poor seedling establishment of directly seeded rice. Antonie Leeuwenhoek 2017, 110, 543–552. [Google Scholar] [CrossRef] [PubMed]
- Abad, Z.G.; Burgess, T.; Bourret, K.; Cacciola, S.O.; Scanu, B.; Mathew, R.; Kasiborski, B.; Srivastava, S.; Kageyama, K.; Buienpfl, J.C.; et al. Phytophthora: Taxonomic and phylogenetic revision of the genus. Stud. Mycol. 2023, 106, 259–348. [Google Scholar] [CrossRef] [PubMed]
- Hendrix, F.F.; Campbell, W.A. Pythiums as plant pathogens. Annu. Rev. Phytopathol. 1973, 11, 77–98. [Google Scholar] [CrossRef]
- Jung, T.; Milenković, I.; Balci, Y.; Janoušek, J.; Kudláček, T.; Nagy, Z.Á.; Baharuddin, B.; Bakonyi, J.; Broders, K.D.; Cacciola, S.O.; et al. Worldwide forest surveys reveal forty-three new species in Phytophthora major Clade 2 with fundamental implications for the evolution and biogeography of the genus and global plant biosecurity. Stud. Mycol. 2024, 107, 251–388. [Google Scholar]
- Hsieh, H.J. An annotated list of Pythium in Taiwan. Bot. Bull. Acad. Sinica 1978, 19, 199–205. [Google Scholar]
- Ventura, F.; Watanabe, I.; Castillo, M.B.; De La Cruz, A. Involvement of nematodes in the soil sickness of a dryland rice-based cropping system. J. Soil Sci. Plant Nutr. 1981, 27, 305–315. [Google Scholar] [CrossRef]
- Chun, S.C. Etiology and Biological Control of Rice Seedling Disease in Water-Seeded Rice. Ph.D. Thesis, Department of Plant Pathology and Crop Physiology, Louisiana State University and Agricultural and Mechanical College, Baton Rouge, LA, USA, 1997. [Google Scholar]
- Chun, S.C.; Schneider, R.W. Sites of infection by Pythium species in rice seedlings and effects of plant age and water depth on disease development. Phytopathology 1998, 88, 1255–1261. [Google Scholar] [CrossRef][Green Version]
- Banaay, C.G.B.; Cuevas, V.C.; Vera Cruz, C.M. Trichoderma ghanense promotes plant growth and controls diseases caused by Pythium arrhenomanes in seedling of aerobic rice variety Apo. Phillip. Agric. Sci. 2012, 95, 175–184. [Google Scholar]
- Zhu, H. Utilization of Rice Bran by Pythium irregulare for Lipid Production. Master’s Thesis, Louisiana State University, Baton Roug, LA, USA, 2002. [Google Scholar]
- Eberle, M.A.; Rothroch, C.S.; Cartwright, R.D. Pythium species associated with rice stand establishment problems in Arkansas. AAES Res. Ser. 2007, 560, 57–63. [Google Scholar]
- Kreye, C.; Bouman, B.; Castañeda, A.R.; Lampayan, R.M.; Faronilo, J.E.; Lactaoen, A.T.; Fernandez, L. Possible causes of yield failure in tropical aerobic rice. Field Crop. Res. 2009, 111, 197–206. [Google Scholar] [CrossRef]
- Oliva, R.; Win, J.; Raffaele, S.; Boutemy, L.; Bozkurt, T.O.; Chaparro-Garcia, A.; Segretin, M.E.; Stam, R.; Schornack, S.; Cano, L.M.; et al. Recent developments in effector biology of filamentous plant pathogens. Cell. Microbiol. 2010, 12, 705–715. [Google Scholar] [CrossRef]
- Van Buyten, E.; Höfte, M. Pythium species from rice roots differ in virulence, host colonization and nutritional profile. BMC Plant Biol. 2013, 13, 203. [Google Scholar] [CrossRef]
- Toda, T.; Lwase, A.; Fuji, S.; Furuya, H. Widespread occurrence of Pythium arrhenomanes pathogenic to rice seedlings around Japanese rice fields. Plant Dis. 2015, 99, 1823–1831. [Google Scholar] [CrossRef]
- Salmaninezhad, F.; Mostowfizadeh-Ghalamfarsa, R. Three new Pythium species from rice paddy fields. Mycologia 2019, 111, 274–290. [Google Scholar] [CrossRef]
- Bolboli, Z.; Mostowfizadeh-Ghalamfarsa, R. Phylogenetic relationships and taxonomic characteristics of Pythium spp. isolates in cereal fields of Fars Province. Iran. J. Plant Pathol. 2015, 51, 471–492. [Google Scholar]
- Salmaninezhad, F.; Mostowfizadeh-Ghalamfarsa, R. Taxonomy, phylogeny and pathogenicity of Pythium species in rice paddy fields of Fars Province. Iran. J. Plant Pathol. 2017, 53, 31–53. [Google Scholar]
- Jeffers, S.N.; Martin, S.B. Comparison of two media selective for Phytophthora and Pythium species. Plant Dis. 1968, 70, 1035–1043. [Google Scholar]
- Tan, K.H. Soil Sampling, Preparation and Analysis; Marcel Dekker Inc.: New York, NY, USA, 1996; pp. 1–408. [Google Scholar]
- Mostowfizadeh-Ghalamfarsa, R.; Banihashemi, Z. Identification of soil Pythium species in Fars Province of Iran. Iran. J. Sci. Technol. 2005, 29, 79–87. [Google Scholar]
- Ho, H.H.; Chen, X.X.; Zeng, H.C.; Zheng, F.C. The occurrence distribution of Pythium species in Hanian south island of China. Bot. Stud. 2012, 53, 525–534. [Google Scholar]
- McLeod, A.; Botha, W.J.; Meitz, J.C.; Spies, C.F.J.; Tewoldemedhin, Y.T.; Mostert, L. Morphological and phylogenetic analysis of Pythium species in South Africa. Mycol. Res. 2009, 113, 933–951. [Google Scholar] [CrossRef] [PubMed]
- Schmitthenner, A.F. Isolation and identification methods for Phytophthora and Pythium. In Proceedings of the Woody Ornamental Disease Workshop, Colombia, MI, USA, 24–25 January 1973; University of Missouri: Colombia, MI, USA; p. 128. [Google Scholar]
- Mirsoleimani, Z.; Mostowfizadeh-Ghalamfarsa, R. Characterization of Phytophthora pistaciae, the causal agent of pistachio gummosis, based on host range, morphology and ribosomal genome. Phytopathol. Mediterr. 2013, 53, 501–506. [Google Scholar]
- Salmaninezhad, F.; Aloi, F.; Pane, A.; Mostowfizadeh-Ghalamfarsa, R.; Cacciola, S.O. Globisporangium coniferarum sp. nov., associated with conifers and Quercus spp. Fungal Syst. Evol. 2022, 10, 127–137. [Google Scholar] [CrossRef] [PubMed]
- Geneious. Available online: https://www.geneious.com (accessed on 6 February 2023).
- Altschul, S.F.W.; Gish, W.; Miller, E.W.; Meyers, E.W.; Lipman, D.J. Basic local alignment search tool. J. Mol. Biol. 1990, 215, 403–410. [Google Scholar] [CrossRef]
- Swofford, D. PAUP*: Phylogenetic Analysis Using Parsimony (*and Other Methods), Version 4.0 b10; Sinauer Associates: Sunderland, MA, USA, 2002. [Google Scholar]
- Ronquist, F.; Huelsenbeck, J.P. MrBayes 3: Bayesian phylogenetic inference under mixed models. Bioinformatics 2003, 19, 1572–1574. [Google Scholar] [CrossRef]
- Mishra, B.; Ploch, S.; Weiland, C.; Thines, M. The TrEase webserver: Inferring phylogenetic trees with ease. Mycol. Progr. 2023, 22, 84–90. [Google Scholar] [CrossRef]
- Tamura, K.; Stecher, G.; Kumar, S. MEGA 11: Molecular evolutionary genetics analysis version 11. Mol. Biol. Evol. 2021, 38, 3022–3027. [Google Scholar] [CrossRef]
- Banihashemi, Z. Study of pistachio gummosis in southern provinces of Iran. In Proceedings of the 9th Iranian Plant Protection Congress, Mashhad, Iran, 9–14 September 1989; p. 87. [Google Scholar]
- Afeck, U.; Sztejnberg, A.; Solel, Z. A rapid method for evaluating citrus seedlings for resistance to root rot caused by Phytophthora citrophthora. Plant Dis. 1990, 74, 66–68. [Google Scholar] [CrossRef]
- Dick, M.W. Keys to Pythium; University of Reading-School of Plant Sciences-Department of Botany: Reading, UK, 1990; p. 68. [Google Scholar]
- Salmaninezhad, F.; Mostowfizadeh-Ghalamfarsa, R. Phenotypic plasticity of the isolates assigned to Pythium plurisporium. Mycol. Iran. 2019, 6, 59–71. [Google Scholar]
- Abad, G.; Shew, H.D.; Grand, L.F.; Lucas, L.T. A new species of Pythium producing multiple oospores isolated from bentgrass in North Carolina. Mycologia 1995, 87, 896–901. [Google Scholar] [CrossRef]
- Paul, B.; Bala, K. A new species of Pythium with inflated sporangia and coiled antheridia, isolated from India. FEMS Microbiol. Lett. 2008, 282, 251–257. [Google Scholar] [CrossRef]
- de Cock, A.W.A.M.; Lodhi, A.M.; Rintoul, T.L.; Bala, K.; Robideau, G.P.; Abad, Z.G.; Coffey, M.D.; Shahzad, S.; Lévesque, C.A. Phytopythium: Molecular phylogeny and systematics. Persoonia 2015, 34, 25–39. [Google Scholar] [CrossRef]
Disclaimer/Publisher’s Note: The statements, opinions and data contained in all publications are solely those of the individual author(s) and contributor(s) and not of MDPI and/or the editor(s). MDPI and/or the editor(s) disclaim responsibility for any injury to people or property resulting from any ideas, methods, instructions or products referred to in the content. |
© 2024 by the authors. Licensee MDPI, Basel, Switzerland. This article is an open access article distributed under the terms and conditions of the Creative Commons Attribution (CC BY) license (https://creativecommons.org/licenses/by/4.0/).